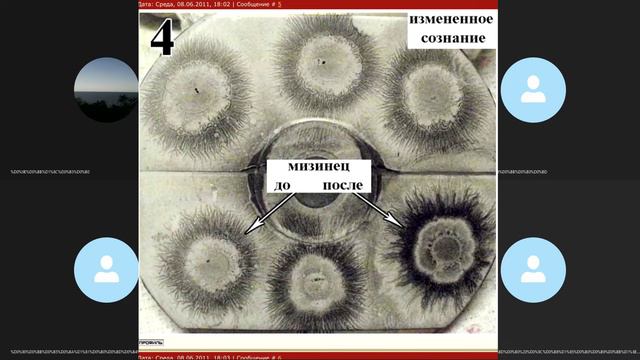
Диагностика Ауроскопом — Конференция №1. Знакомство с методикой. смотреть онлайн

Автор / Канал: Quiz Quarters Страница 6

Екатерина Чумаченко - А на последок я скажу

Warface. К.д игры 2.6 Карта сибирь, Выживание.

1 парта

ewan mcgregor as private hopper | blinding lights

Бузова съемки клипа на песню "Принимай меня"❤️скоро будет премьера

ТАЧКИ 2 я выиграл и занял 1 место 4 часть

мы сделали самый лучший дом посмотрите.

Scorpions - Maybe I, Maybe You (Russian Language Cover)

Артем Акопянц 2

БОЛЬШАЯ ПОБЕДА ► Elden Ring Прохождение #12

Призрак хотел обнимашек в Phasmophobia

Белла Кабалоева " Чызгайы фынта" Сл и муз. Ж.Дзиццоева

Константин Кинст и Авнэр Вэриус – Ветер надежды (ноктюрн)

~ моя мама научила~ Кристина Захарова

Arsenal ДУЛО | Roblox

Чёрный ворон. Песня. Без музыки.

Иида и знаки by VOX.cube | BNHA | Iida

Кто твой папочка в маинкрафте

БЛОГЕРЫ ПО ВАНПАНЧМЕНУ ПРОТИВ ПО КЛИНКУ РАССЕКАЮЩЕМУ ДЕМОНОВ

Моя песня. "Снег на ладонях". Автор и исполнитель. 31.05.22г.

Кто ты по имени из Котов-Воителей. 18 часть

Де Йонг + Депай - Куман | Барселона - Хетафе 2:1

«Я придумаю тебя» исполняет Ирина Фрёлих
Диагностика Ауроскопом — Конференция №1. Знакомство с методикой.
За каждым успешным каналом стоит личность, идея и сотни часов кропотливого труда. Если вы здесь, значит, автор «Quiz Quarters» уже сумел зацепить ваше внимание своим уникальным стилем или подачей. А мы на RUVIDEO позаботились о том, чтобы вы могли изучить весь архив его работ в максимально комфортных условиях — без лишней суеты и преград.
Почему за работами канала «Quiz Quarters» так интересно наблюдать? Всё просто: это честный контент, который находит отклик в сердцах зрителей. На нашем ресурсе вы можете смотреть онлайн все видео любимого автора бесплатно и в хорошем качестве. Нам важно, чтобы вы видели каждую деталь и слышали каждый нюанс, поэтому мы используем только стабильные плееры из открытых источников Rutube.
Следите за новинками канала, пересматривайте старые шедевры и открывайте для себя новые грани творчества «Quiz Quarters». Мы постоянно обновляем ленту, чтобы у вас под рукой всегда были самые свежие выпуски. Никаких сложных регистраций — только вы и творчество, которое вдохновляет. Приятного вам путешествия по миру авторского контента на RUVIDEO!
Видео взято из открытых источников Rutube. Если вы правообладатель, обратитесь к первоисточнику.